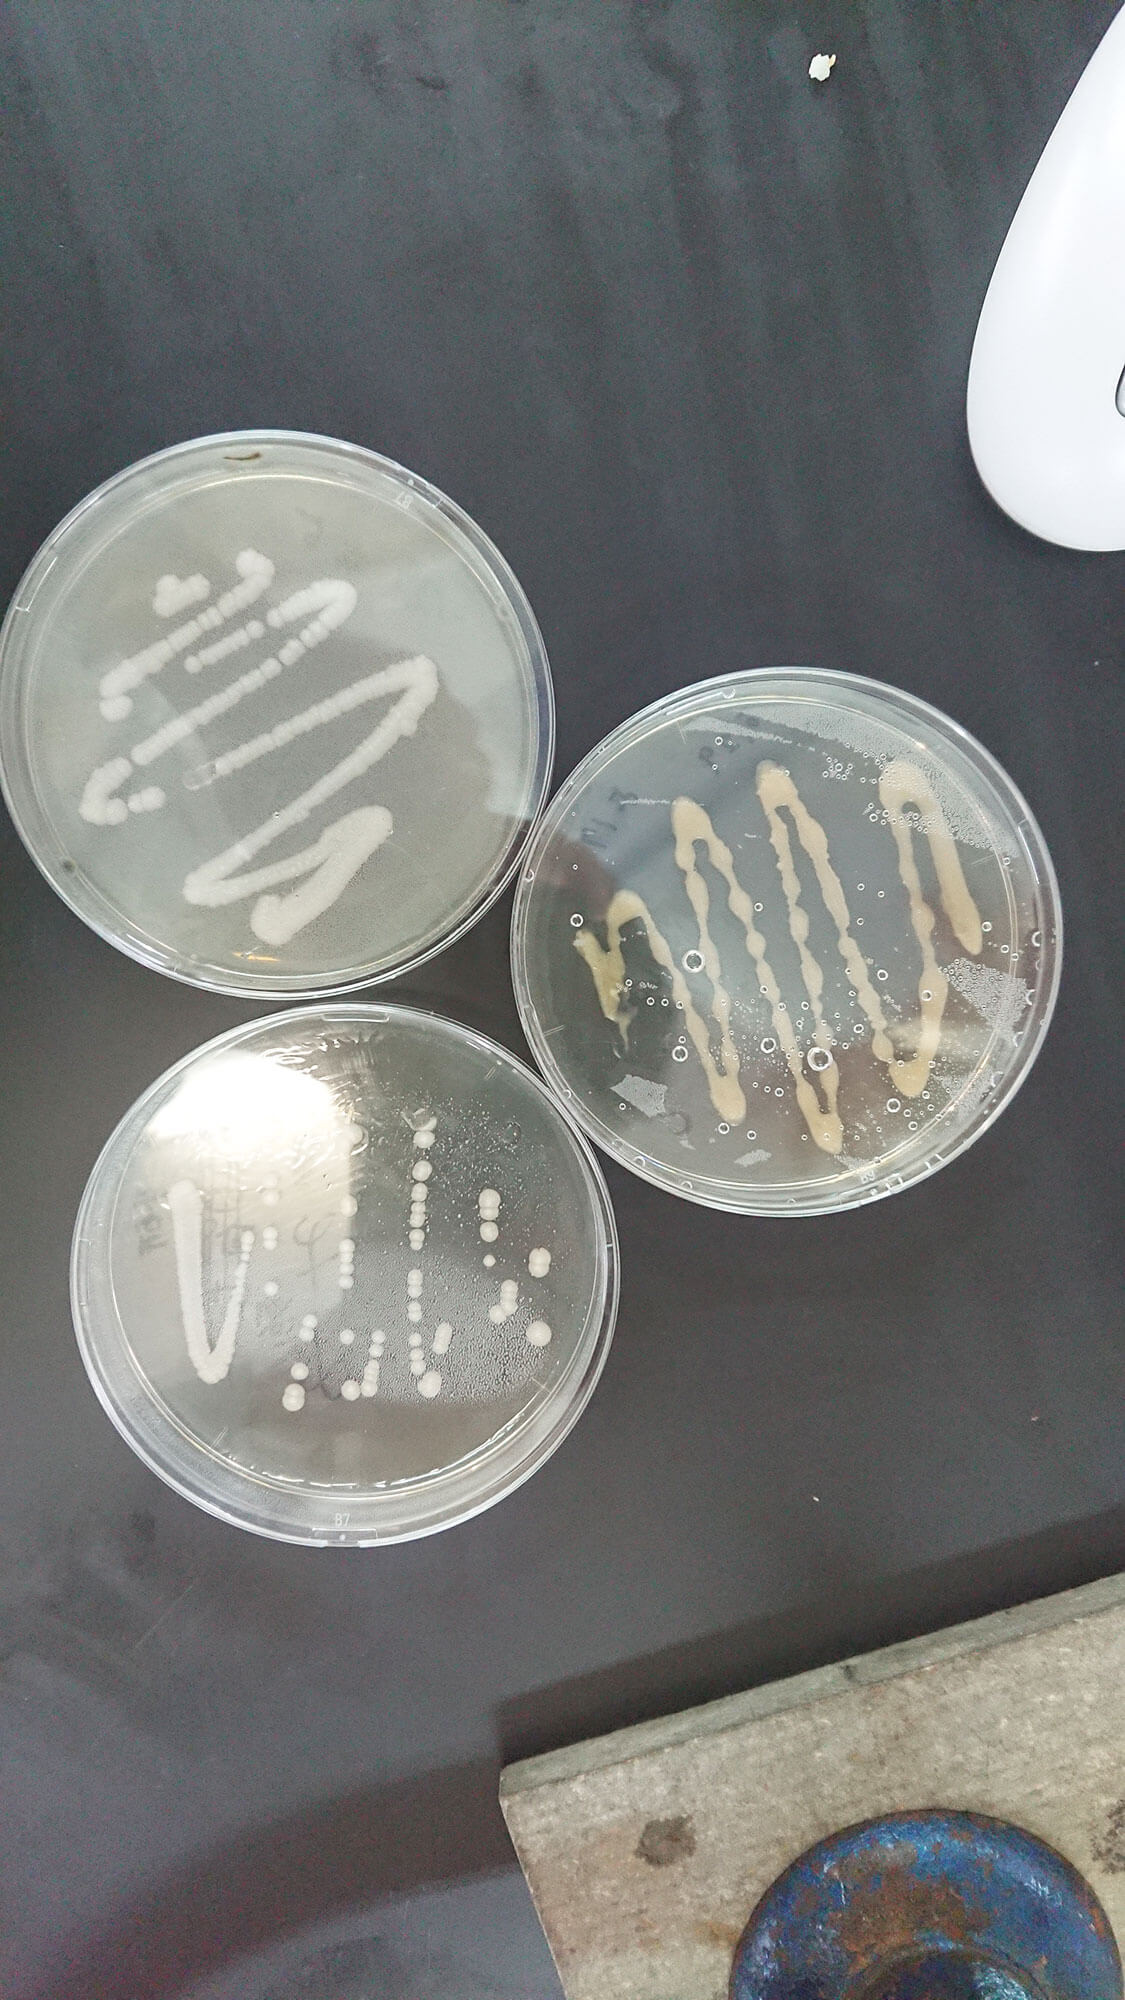

明治から続くyedo(えど)酵母
東京産の酵母として、
1898(明治31)年以前に発見されて、
純粋培養されてきたのが「yedo(えど)酵母」です。
当時、北区滝野川に醸造試験所という国の施設があって、
yedo酵母は、大正、昭和から平成へと
受け継がれていたんですね。
私が酵母の研究をしているなかで、
東京都の食品技術センターの先生が
「千葉県の研究機関に
yedo酵母が保存されている」
と発表したんですよ。
私はすぐにその先生に電話をかけて、
「ぜひ使ってみたい」ということで入手しました。
テストしてみると、デリケートな酵母でしたが、
温度や浸透圧をうまくコントロールしてあげると、
おいしいお酒ができることがわかりました。
「yedo酵母」を使っているので、
お酒の名前を「オール江戸」にして、
東京の酒米と東京の水を使って
日本酒づくりをスタートしよう、
ということになりました。
結果、できあがった日本酒は、
ほんとうに評判がよくて。
いま、日本酒の流行りは
リンゴやバナナの香りがするという方向性ですが、
「オール江戸」は、そうではなく、非常にスタンダード。
味も香りもまろやかで、食事にすごく合うお酒で、
とくに女性に大人気になる酒質に仕上がりました。

日比谷公園のハチから酵母をみつけた!
もうひとつの東京産の酵母は、
じつは学生が発見したものなんですよ。
東京都大田区にある
「東京バイオテクノロジー専門学校」と、
産学連携の取り組みをしたんです。
お互いに東京にいるので、
東京に由来のある酵母を見つけましょう!
というテーマで、2018年の春から、
学生のみなさんが東京のあちこちで
酵母さがしを始めました。
学校の近くの草むらや、江戸城の石垣の中とか、
樹齢300年の木の樹皮の中とか、
いろいろな場所でとってきた酵母が300くらい、
試験管に入れた状態で集まりました。

学生さんが集めた300の検体を、
酵母が一番好きな状態のお粥みたいな培地に少し入れて、
まずは、泡をプクプク出して、
発酵するものだけを選抜。
その発酵にもいろいろな種類があって、
選抜したなかから、
アルコール発酵をするものを探して
18検体まで絞り込みました。
最後は小さいポットで、
実際にお酒を作るテストをして、
人間にとって害がないものであることを
明確にする検査を行なったうえで、
私と学生たちで、味や香りを調べました。
「利き酒」ですね。
そうして、9検体から2検体まで絞り込みました。
さて、どっちにしようか?
みんなで相談したうえで勝ち抜いたのは、
ワイン酵母に近い種族の酵母。
これが現在も使っている「tokyo酵母」です。
この酵母でつくるお酒は、
酸度が高くて香りと味が優れています。
味がしっかりガッツリと出るお酒になる。
それが、この酵母を選んだ決め手でした。

この「tokyo酵母」、
どこでとれたと思いますか?
生徒さんが日比谷公園の花壇にいた
ハナバチから採取してきたものです。
もちろんハチが酵母を生み出したわけじゃなくて、
花を転々として蜜と花粉を集めるときに、
花についていた酵母をもってきたんだと思います。
ハナバチが届けてくれた東京の花の酵母が
おいしいお酒を作ってくれました。
ぼくらはその酵母を愛情をこめて
「ぶんぶん酵母」とも呼んでいます。
こうして2021年2月に発売したのが
「純米吟醸原酒 江戸開城 All Tokyo」です。
野生の酵母(微生物)っていろいろな場所にいるんです。
私たちはそうした微生物に囲まれて生きてます。
そのなかで人間にとってプラスの働きをするものを使って、
お漬物、味噌、お醤油、お酒などをつくっています。
有用な微生物を純粋培養して、お酒をつくることは、
すごく神秘的なことでもあります。
(つづきます)
取材・文:金澤一嘉